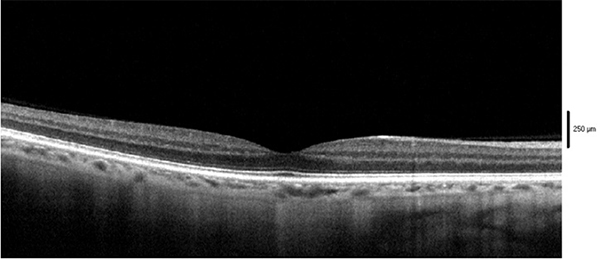

Anno XIII, Numero 3 - ottobre 2019
- GUIDA ALLA CONOSCENZA DELLE PRINCIPALI PATOLOGIE RETINICHE
Una serie di articoli sulle principali patologie retiniche scritti da Ortottisti di provata esperienza
Parte I - Dalla fisiopatologia all'identificazione del paziente
La retina può essere colpita da patologie di diverso tipo: vascolari, ereditarie, infiammatorie, degenerative ecc. Alcune di queste, negli anni, sono diventate molto diffuse e hanno attirato su di loro l'attenzione di molti studi e soprattutto lo sviluppo di nuove terapie. Le patologie che colpiscono la retina, infatti, vanno subito diagnosticate e trattate per evitare un rapido decadimento della funzione visiva.
FONDAMENTI DI ANATOMIA
- foglietto esterno (epitelio pigmentato)
- foglietto interno (retina sensoriale).
La retina è formata da più strati di cellule, ognuno con una funzione specifica che va dalla percezione luminosa alla sua trasformazione in un impulso, che viene inviato al cervello attraverso il nervo ottico. Le cellule deputate alla trasformazione della luce in stimolo nervoso sono i fotorecettori, ovvero i coni e i bastoncelli. Nella retina abbiamo circa 120 milioni di bastoncelli e 6,3-6,4 milioni di coni, questi ultimi presenti maggiormente nella zona chiamata macula e deputati alla visione discriminata dei colori; i bastoncelli sono invece più presenti in periferia, aumentano il campo visivo, ma sono deputati ad una visione più grossolana.
La macula è la porzione centrale della retina. Ha un diametro di circa 5 mm ed è posta temporalmente alla papilla ottica; essa garantisce la percezione delle forme e viene suddivisa in:
- foveola (0,35 mm)
- fovea (depressione centrale 1,5 mm)
- parafovea (anello di circa 0,5 mm che circonda la zona foveale)
- perifovea (1,5 mm).
PRINCIPALI PATOLOGIE RETINICHE
Edema maculare diabetico (DME)
Occlusione venosa retinica di branca (BRVO)
- età: nel 50% dei casi avviene in soggetti di età >65 anni
- ipertensione: presente nei 2/3 dei casi
- dislipidemia: presente in 1/3 dei pazienti
- diabete mellito: può essere presente nel 15% dei soggetti con BRVO di età >50 anni
- contraccettivi orali: nelle donne giovani, i contraccettivi orali rappresentano una associazione molto probabile e non devono essere assunti in caso di BRVO
- fumo di sigaretta: si associa a un'evidenza di aumento di occlusione venosa.
se la macula è coinvolta, il paziente lamenterà visione offuscata o metamorfopsie; se è periferica può essere asintomatica.
Segni:
- aumento della dilatazione e della tortuosità del segmento venoso interessato
- emorragie a fiamma o puntiformi
- il sito dell'occlusione è indentificabile con un incrocio artero/venoso
- edema maculare (che è la causa di scarsa acuità visiva)
- la neovascolarizzazione retinica si verifica nell'8% degli occhi entro 3 anni.
Occlusione della vena centrale della retina (CRVO)
Sintomi:
improvvisa e severa diminuzione dell'acuità visiva. Occasionalmente ci può essere dolore a causa del glaucoma neovascolare, che può svilupparsi entro 3 mesi dall'insorgenza della malattia.
Segni:
- severo aumento della tortuosità vasale
- estese emorragie a fiamma e puntiformi, che coinvolgono la periferia e il polo posteriore
- essudati cotonosi
- la neovascolarizzazione retinica avviene nel 5% degli occhi
- ipofluorescenza alla FAG, in corrispondenza delle aree ischemiche.
Degenerazione maculare neovascolare correlata all'età (DMLE)
Questa patologia è classificata in due forme:
- non essudativa o secca: è la forma più comune (circa il 90% dei casi), caratterizzata dalla presenza di drusen dure e, nelle forme più avanzate, da un'atrofia geografica. I sintomi consistono in un graduale calo dell'acuità visiva nel corso dei mesi o di anni; entrambi gli occhi sono di solito affetti, ma spesso in maniera asimmetrica. La visione può essere fluttuante e spesso è migliore con la luce intensa;
- essudativa o umida: è meno frequente e si associa ad una rapida evoluzione; si caratterizza, oltre che per la presenza di drusen, anche per lo sviluppo di una neovascolarizzazione che provoca l'accumulo di edema e sangue nei tessuti. I sintomi consistono in un improvviso ed acuto calo dell'acuità visiva.
- età (il fattore di rischio maggiore)
- razza (più comune nella razza bianca che nelle altre razze)
- fumo di sigaretta
- ipertensione arteriosa
- obesità.
Neovascolarizzazione coroideale miopica (CNV miopica)
I fattori di rischio della CNV miopica si distinguono in oculari:
- atrofia in sede maculare
- assottigliamento coroideale
- crescente miotico maculare
- lacquer cracks (interruzioni lineari della membrana di Bruch)
- fenomeni infiammatori (citochine, interleuchine 6 e 8)
- fattori genetici
- ipertensione sistolica.
- piccolo nodulo pigmentato o rossastro sotto la retina, spesso circondato da anello pigmentato con emorragia maculare
- spot iperpigmentato maculare (macchia di Fuchs).
DIAGNOSI
Acuità visiva:
rappresenta l'esame in grado di quantificare la capacità visiva di un paziente. Può essere eseguito con diversi tipi di ottotipi, quelli più comuni sono gli ottotipi a progressione aritmetica. Per le acuità visive più basse sono stati introdotte le tavole ottotipiche a progressione geometrica (logaritmica o logMAR), in cui l'incremento della grandezza dei simboli è percentualmente costante con le lettere di ogni riga, 1,28 volte più grandi di quelle della riga successiva.
il reticolo di Amsler valuta i 20° del campo visivo centrale ed è utilizzato soprattutto nello screening e nel monitoraggio delle maculopatie. Il più comune è il reticolo con linee verticali e orizzontali bianche su sfondo nero, dove ogni singolo quadrato della griglia sottende un angolo di 1°. Il paziente indossando gli occhiali da lettura guarderà il punto centrale e dovrà osservare se le linee appaiono ondulate o distorte.
è un esame funzionale della sensibilità retinica centrale e valuta la sede della fissazione, in relazione alla fovea anatomica. Permette la simultanea visualizzazione del fondo oculare, insieme alla stimolazione di aree retiniche specifiche, correlando così i dati perimetrici ottenuti con le alterazioni morfologiche esistenti. ?? molto utile in pazienti affetti da maculopatie degenerative sia a scopo diagnostico, per valutare il danno maculare, sia a scopo riabilitativo, per indurre una fissazione nuovamente stabile, anche se eccentrica, su aree non affette dalla patologia.
Permette di valutare la funzionalità dei coni, soprattutto in regione maculare. Lo schermo presenta uno stimolo a scacchiera costituito da 61-241 esagoni che occupano 25° del campo visivo. Questa tecnica permette di valutare la funzione delle cellule retiniche in zona maculare, riuscendo a fornire all'esaminatore diverse mappe.
La tomografia a coerenza ottica (OCT) è una metodica di imaging retinico non invasiva, non a contatto, che permette lo studio di sezioni retiniche ad alta risoluzione. Si basa sul principio dell'interferometria a bassa coerenza. L'esame, attraverso una luce laser a bassa coerenza, valuta la reflettività dei vari strati retinici in modo da permettere la visualizzazione di eventuali alterazioni patologiche. Le immagini, ottenute secondo i diversi piani di scansione (verticale e orizzontale), consentono uno studio completo della regione maculare e della papilla ottica. I nuovi apparecchi hanno permesso, attraverso una velocità delle scansioni aumentata, la riduzione degli artefatti e un aumento della risoluzione.
unisce alle scansioni OCT lo studio della rete vascolare retinica e coroideale. L'esame, attraverso lo studio della differenza di reflettività nelle scansioni provocate dal moto dei globuli rossi nei vasi, consente un ricostruzione della rete vascolare. ?? una tecnica diagnostica di ultima generazione, che ci permette di avere esami ad altissima risoluzione. Gli apparecchi sono dotati di un sistema di eye-tracking, un sistema di puntamento oculare che riduce la possibilità di artefatti da movimento. ?? molto utile nelle forme di maculopatia per valutare l'eventuale sviluppo di una neovascolarizzazione.
è una tecnica diagnostica che si basa sull'iniezione di un colorante, la Fluoresceina sodica, e che attraverso un apparecchio digitale, ne studia il flusso all'interno della rete vascolare retinica. Durante l'esame, è possibile visualizzare le alterazioni patologiche della retina con vari tipi di iperfluorescenze o ipofluorescenze, fino all'assenza della normale fluorescenza, determinata dal colorante iniettato.
è una tecnica diagnostica simile alla fluorangiografia, ma si differenzia per il colorante usato: si utilizza infatti il verde di indocianina, ovvero un colorante più adatto ad analizzare la rete vascolare coroideale per valutare le patologie che interessano la coroide.
PRINCIPALI DIFFERENZE TRA LE CINQUE PATOLOGIE
I CONSIGLI DELL'ORTOTTISTA
- l'alimentazione non deve trascurare i vegetali contenenti carotenoidi come spinaci, lattuga, cavoli verdi, cavoletti di Bruxelles, broccoli; pomodori, piselli e carote non devono mancare in virtù del loro contenuto in componenti utili per la retina
- in caso di diabete tenere sotto stretto controllo la glicemia; ricordare che la dieta prescritta dal medico è parte integrante della terapia medica e deve essere quindi seguita in maniera scrupolosa
- concordare con il proprio medico un programma di esami di laboratorio, indagini strumentali e visite di controllo, in modo da valutare l'andamento della patologia e monitorare la propria acuità visiva
- riportare e descrivere eventuali nuovi sintomi
- il fumo va completamente abolito
- indossare occhiali da sole protettivi soprattutto nelle ore centrali della giornata e nella stagione calda
- negli spostamenti a piedi, seguire sempre gli stessi itinerari, cercare di memorizzare semafori ed ostacoli ed eventuali tratti di strada pericolosi o insidiosi
- cercare percorsi in cui il sole è di spalle e non di fronte
- nell'ambiente domestico, organizzare la casa in modo da potersi muovere agilmente (ad esempio, collocare i mobili lungo le pareti evitando ingombri lungo il percorso tra una stanza e l'altra; evitare tappeti ed illuminare bene locali, corridoi, ripostigli, scalinate e, se possibile, l'interno dei mobili).
PUNTI CHIAVE
- Le patologie retiniche sono tra le maggiori cause di ipovisione e cecità in tutto il mondo, con costi per i trattamenti molto alti.
- Le tecniche diagnostiche e terapeutiche sono continuamente in evoluzione, per velocizzare i tempi di diagnosi, migliorarne il trattamento e diminuirne i costi.
- La diagnosi precoce e il corretto trattamento delle patologie retiniche sono fondamentali per preservare la funzionalità visiva del paziente.
- Un corretto stile di vita migliora l'efficacia dei trattamenti e previene il peggioramento repentino del quadro patologico.
Carlo Perillo
Ortottista ed assistente in Oftalmologia, Napoli
Bibliografia di riferimento
- Kanski J, Bowling B. Kanski's Clinical Ophthalmology (8th Edition) - A Systematic Approach. Saunders Ltd. 2015.
- Traverso CE et al. Clinica dell'apparato visivo (II edizione). Edra. 2015.
- Yanoff M, Duker JS. Trattato di oftalmologia. Antonio Delfino Editore. 2003.